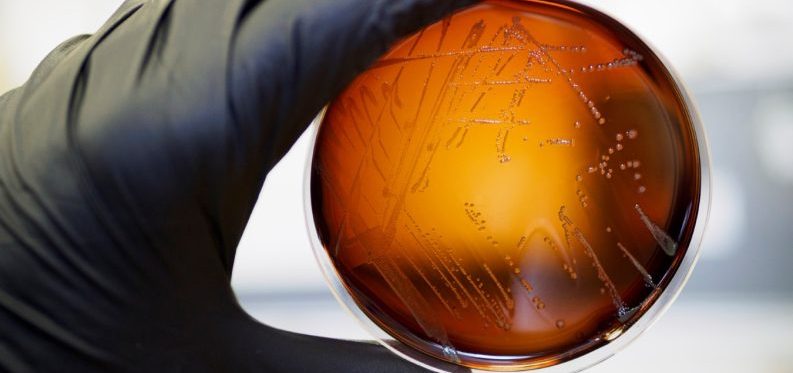
Food,Safety,Pathogen,Listeria,Monocytogenes,Isolated,On,Agar,From,A

Alles over listeria monocytogenes
Listeria is de algemene naam van een bacterie met meerdere soorten. Listeria monocytogenes is een risicovol ziekteverwekkend micro-organisme dat zelfs kan groeien bij lage temperaturen.
Listeria monocytogenes kan de infectieziekte listeriose veroorzaken. Dat hangt af van de hoeveelheid bacteriën in een product en de gevoeligheid van de persoon. Vooral baby’s en jonge kinderen, zwangere vrouwen, ouderen en mensen met een verminderde weerstand lopen risico wanneer zij producten eten waarin te veel Listeria monocytogenes aanwezig is.
Listeria monocytogenes is voor veel bederfelijke producten die in koeling gehouden worden het eerste risico. Het is daarom belangrijk dat de groei van Listeria monocytogenes tijdens de houdbaarheidstermijn binnen de norm blijft.
Verordening (EG) Nr. 2073/2005 stelt de wettelijke microbiologische criteria vast voor levensmiddelen en bepaalt wanneer en hoe bedrijven moeten testen om te controleren of hun producten veilig zijn. De verordening geeft onder meer regels voor bacteriën zoals Listeria monocytogenes, Salmonella en E. coli.
Per 1 juli 2026 worden de microbiologische criteria in Verordening (EG) nr. 2073/2005 aangescherpt, met specifieke aandacht voor Listeria monocytogenes.
De wijziging geldt uitsluitend voor foodcategorie 1.2: kant-en-klare levensmiddelen die als voedingsbodem kunnen dienen voor deze bacterie. Vanaf die datum moet Listeria monocytogenes afwezig zijn in 25 gram product wanneer een bedrijf geen houdbaarheidsstudie heeft uitgevoerd.
Bedrijven die wél een onderbouwde studie hebben, mogen aantonen dat de bacterie gedurende de hele houdbaarheid onder de grens van 100 kve/g blijft. Daarbij moet direct na productie worden getoetst aan een strenger criterium, zoals afwezigheid in 25 gram of een passende intermediaire grenswaarde die garandeert dat het product aan het einde van de houdbaarheid niet boven 100 kve/g uitkomt.
Bovendien wordt het eerdere onderscheid tussen verificatie “onder controle van de producent” en “in de handel” losgelaten, waardoor voor beide situaties dezelfde criteria gaan gelden.
Criteria tot 1 juli 2026:
Product onder controle producent (dus nog in de fabriek)
- Zonder studie: Listeria monocytogenes afwezig in een monster van 25 g
- Met studie: Listeria monocytogenes afwezig in x gram of ≤ x kve/g (dit kan een intermediaire grenswaarde zijn)
Product in de handel
- Zonder studie: Afhankelijk van risico-inschatting
- Met studie: ≤ 100 kve/g
Criteria vanaf 1 juli 2026:
- Zonder studie: Listeria monocytogenes afwezig in een monster 25 g
- Met studie: ≤ 100 kve/g (met inachtneming van een eventuele intermediaire grenswaarde)
De criteria zijn vanaf 1 juli 2026 uniform, ongeacht of het product onder controle van de producent is of in de handel. De eis ‘afwezig in 25 gram’ geldt vanaf 1 juli 2026 ook in de handel. De regels voor Listeria monocytogenes worden dus aangescherpt.
Vo. (EG) 2073/2005 (en de wijziging Vo. (EU) 2024/2895) is van toepassing op bedrijven die gebruikmaken van een hygiënecode en hoofdzakelijk leveren aan andere bedrijven.
De verordeningen gelden ook voor formulebedrijven en privatelabelhouders. Deze bedrijven moeten een eigen aanvulling opstellen voor de onderdelen die niet zijn uitgewerkt in hun hygiënecode. Deze eigen aanvulling is niet nodig wanneer de hygiënecode van hun sector al volledig en aantoonbaar voldoet aan de aanvullende eisen van de Europese verordening.
Ook importeurs, handelaren, distributeurs en bedrijven in de verwerkende industrie zijn verplicht Vo. 2073/2005 te volgen.
Bedrijven die met een hygiënecode werken en vooral direct aan consumenten verkopen, hoeven geen verificatie (zoals monstername of laboratoriumonderzoek) uit te voeren volgens Vo. 2073/2005. Dit geldt ook als deze bedrijven slechts in beperkte mate leveren aan andere detailhandel waarvoor geen NVWA-erkenning nodig is. De maatregelen in de hygiënecode zijn dan voldoende om de voedselveiligheid te waarborgen. Dit betekent niet dat de microbiologische criteria niet gelden. Als er bijvoorbeeld Salmonella wordt gevonden in een vleesbereiding bij een slager, dan is dat product onveilig en mag het niet verkocht worden.
Als het gaat om monsters van de productie-omgeving, wordt de eis van vier keer per jaar tien monsters losgelaten. In plaats daarvan wordt de frequentie bepaald aan de hand van een risico-inventarisatie van de gehele productie-omgeving. De bouwkundige staat is daarbij van belang, maar ook machine-onderdelen en of er sprake kan zijn van (kruis) besmetting van niet verpakte producten. De risico-inventarisatie moet allesomvattend zijn.
De bemonsteringsfrequentie voor proceshygiënecriteria wordt afgestemd op de aard en de omvang van het levensmiddelenbedrijf. Het Handboek Levensmiddelenmicrobiologie maakt onderscheid tussen:
- Grote bedrijven, die binnen Nederland op grote schaal produceren voor de internationale markt
- Middelgrote bedrijven, die een eigen (aanvullend) HACCP-plan hebben en geen groot bedrijf zijn
- Kleine bedrijven in de ambachtelijke sector/horeca/overige. Hiervoor zijn met name hygiënecodes van toepassing
Tabel 8 van Handboek Levensmiddelenmicrobiologie geeft de testfrequentie weer. Bij middelgrote bedrijven in de risicocategorie ‘middel’ gaat het bijvoorbeeld om één keer per twee maanden. In risicocategorie ‘hoog’ is het één keer per twee weken. Het gaat daarbij om productgroepen, dus niet alle producten hoeven in deze frequenties onderzocht te worden.
(Voor kleine pluimveeslachthuizen en roodvleesslachterijen gelden andere regels)
Het is vooral belangrijk om het proces zodanig in te richten dat de kans op een listeriabesmetting zo klein mogelijk is. Dat zit in heel veel gevallen in ‘gewoon’ goed onderhoud van de bedrijfsruimtes en zorgvuldig volgen van hygiënische werkwijzen. Als uit de trendanalyse en het omgevingsonderzoek blijkt dat er geen listeria in de bedrijfsruimte aanwezig is, kan die ook niet verspreid worden. Dan kan het alleen nog via grondstoffen binnengehaald worden. Een zorgvuldig proces kan (kruis)besmetting en/of uitgroei voorkomen.
Bedrijven die geen listeriabeheersplan hebben, moeten dat wel gaan opstellen. Daarvoor zal in de eerste periode mogelijk extra productonderzoek nodig zijn om aan te tonen dat het proces ook daadwerkelijk voldoet aan de criteria.
Het Handboek Levensmiddelenmicrobiologie van de NVWA legt uit hoe bedrijven hun producten moeten testen.
- Aantal monsters: n=5, c=0 (pagina 30, 34 en 37)
- Kwalitatieve en kwantitatieve tests: nooit gescheiden, wel tegelijk in zelfde deelmonster (pagina 35)
- Testfrequentie: risicogericht, soms wettelijke minimale frequentie (pagina 35)
- Moment van testen: HACCP-bepaald, vaak direct na productie (pagina 35-36)
- Analysemethode: Wettelijke referentiemethode (ISO 11290) (pagina 35)
- Criteria Listeria zonder studie: afwezig in 25 g (n=5, c=o) (pagina 30, 37)
- Criteria Listeria met studie: ≤100 kve/g gedurende houdbaarheid; intermediaire grenswaarde bij start (pagina 30, 37)
- Analyses moeten worden uitgevoerd door een geaccrediteerd laboratorium
- Voor Nederlandse laboratoria moet de accreditatie worden verleend door de Raad voor Accreditatie (RvA).
- Het nemen van de monsters hoeft niet onder accreditatie te gebeuren.
Verordening (EG) Nr. 2073/2005
Dit is de verordening uit 2005 met de wettelijke microbiologische criteria.
Verordening (EU) 2024/2895
Dit is de wijzigingsverordening die vanaf 1 juli 2026 geldt. Deze verordening verandert uitsluitend de criteria voor categorie 1.2 (kant-en-klare levensmiddelen die als voedingsbodem kunnen dienen).
Handboek Levensmiddelenmicrobiologie (download)
Dit handboek van de NVWA is bedoeld als hulpmiddel voor levensmiddelenbedrijven en geeft een praktische uitleg van de wetgeving. Het handboek is de opvolger van Informatieblad 85.
